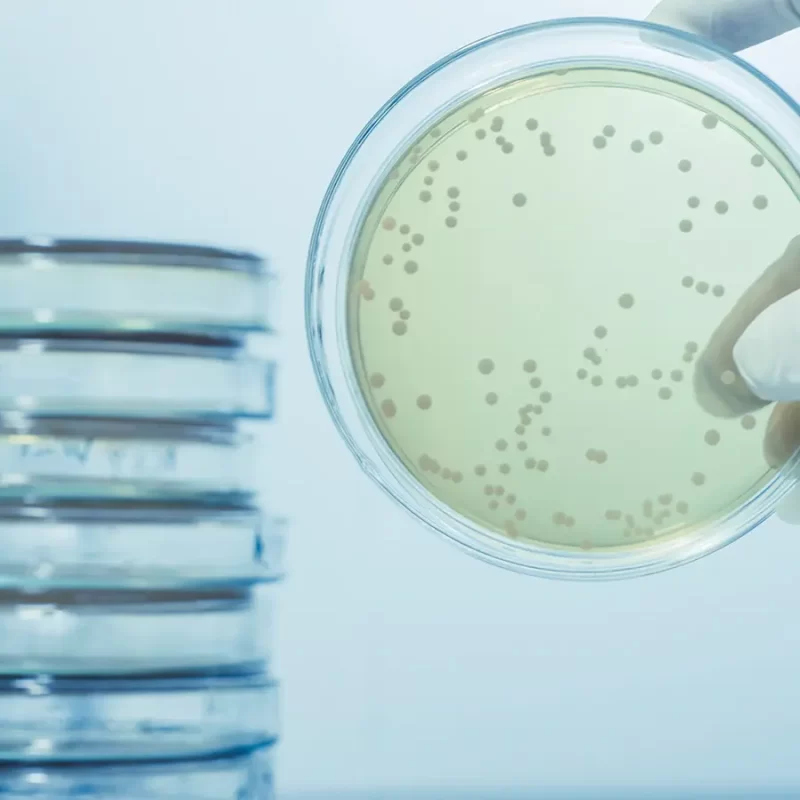
Legionella Control - Scotmas - Chlorine Dioxide Specialist.

At Scotmas, we are dedicated to keeping people and the environment safe.
Controlling dangerous infections and contamination is possible without compromising the wider environment.
Focusing on continuous innovation and development, we strive to create new technology that leads to products and services that can purify water, protect against dangerous contamination and disease, and enable our customers to perform at their best.
Mission – We keep people and the environment safe. We effectively control dangerous microorganisms and pathogens whilst minimising harm to the environment.
Vision – To be the first-choice provider of environmentally sustainable water treatment, hygiene and environmental care systems within our chosen market sectors.
Our team is committed to displaying…
Innovation – We learn to do things better. We embrace new technologies, processes, and businesses models to deliver long term value.
Passion – What we do matters. We care about protecting customers and the environment, and work every day to do things safer, faster, better.
Openness – We embrace new people, cultures and ideas. We work collaboratively with others to achieve our goals. Share, be comfortable, care.
These values are essential to providing high-quality solutions to our clients.
Whether you’re looking for water purification systems or any other product that can help you maintain a safe and healthy environment, you can count on us to provide reliable and effective options. So, if you’re looking for a partner dedicated to your safety and well-being, look no further than Scotmas.